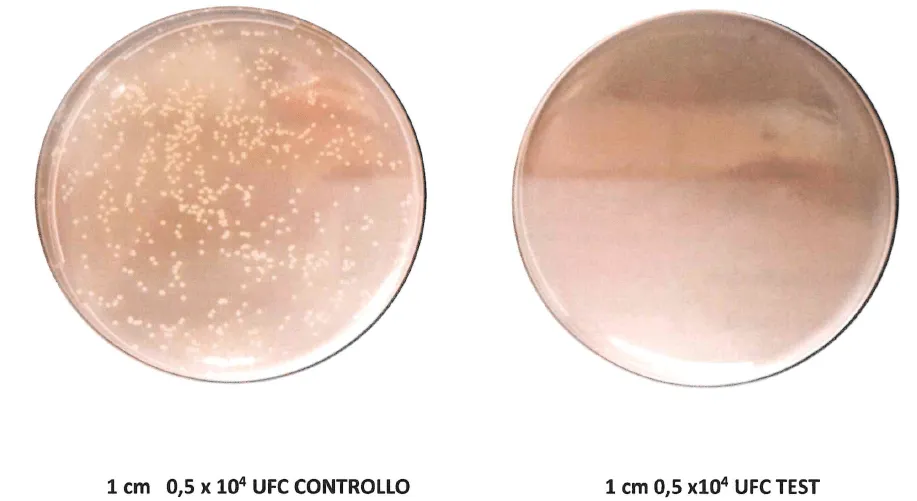
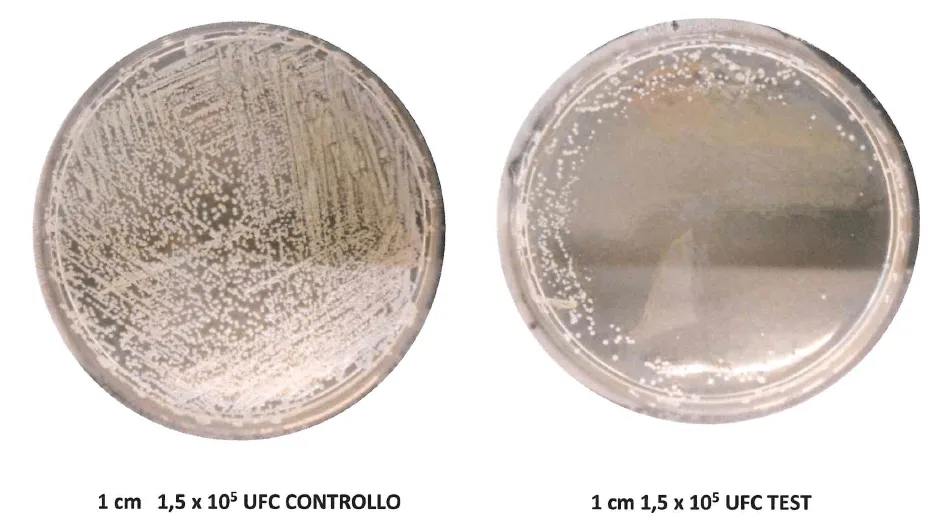
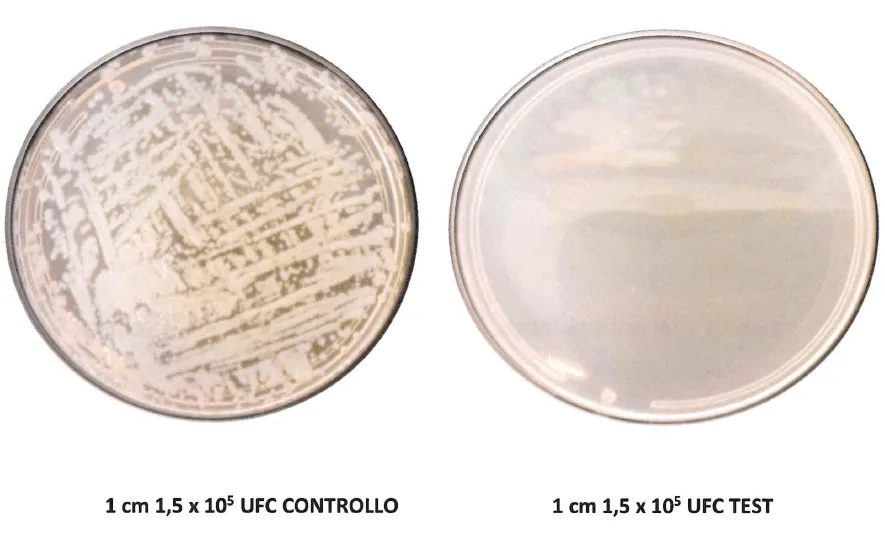

ATTENZIONE OPPORTUNITA’ BLINDATA
ACCESSO RISTRETTO A SOLI 100 PARTNER ONNWATER
SERIAMENTE MOTIVATI A DOMINARE IL PROPRIO MERCATO
. . .NON UNO DI PIU’.
Il Genio Paolo Tesi Inventa Quasi per Caso TYFON®:
IL PRIMO SISTEMA D’IGIENE PER EROGATORI
D’ACQUA MEDICALMENTE CERTIFICATO CHE TI
ELIMINA PER SEMPRE L’ANSIA DELLA
RETRO-CONTAMINAZIONE BATTERICA
Il Genio Paolo Tesi Inventa Quasi per Caso TYFON®:
IL PRIMO SISTEMA D’IGIENE PER EROGATORI
D’ACQUA MEDICALMENTE CERTIFICATO CHE TI ELIMINA PER SEMPRE L’ANSIA DELLA
RETRO-CONTAMINAZIONE BATTERICA
Senza Usare Lampade UV in Uscita. . .Senza
Generatori di Ozono . . . 100% Automatico e Senza
Manutenzioni da Gestire.
"Traffic Secrets: New FREE Book
Reveals How To Fill Your Website and Funnels With Your Dream Customers..."






Reserve Your FREE Copy Of 'Traffic Secrets' Today!
Need more traffic to your website or funnel?
"New FREE BOOK Shows 20+ Virtually UNKNOWN Secrets To Get Tons Of Traffic To *Any* Website..."




Need more traffic to your website or funnel?
"New FREE BOOK Shows
20+ Virtually UNKNOWN Secrets
To Get Tons Of Traffic To *Any* Website or Funnel..."
Send Me Your Address
I'd like to rush a FREE copy of my brand new hardcover book to your doorstep, ASAP.

TYFON® è la prima vera innovazione scientifica e certificata nell’igiene degli erogatori d’acqua degli ultimi 50 anni.
Un sistema così avanzato da eliminare – direttamente dall’ugello – batteri pericolosi e disgustosi come Pseudomonas aeruginosa, Staphylococcus aureus e Saccharomyces cerevisiae, che contaminano l’erogatore e l’acqua in uscita
Non fa rumore, non ha odore, non altera il gusto dell’acqua, si attiva in automatico dopo ogni erogazione ed è incredibilmente facile da proporre anche alla “Signora Maria”
È talmente più all’avanguardia e semplice delle classiche soluzioni, quanto un jet lo è rispetto a una carrozza a cavalli.
Incredibili Foto Prima/Dopo Che Mostrano La
Potenza Di Tyfon®
Sui Batteri Più Pericolosi Per I Tuoi Clienti
(E Per La Tua Reputazione Sul Mercato)
Incredibili Foto Prima/Dopo Che Mostrano La Potenza Di Tyfon®
Sui Batteri Più Pericolosi
Per I Tuoi Clienti
(E Per La Tua Reputazione Sul Mercato)
PRIMA vs. DOPO
Nella prima immagine a sinistra,
osserva come il piatto è completamente invaso da colonie di Staphylococcus aureus, uno dei batteri più pericolosi per la salute umana, spesso presente sugli ugelli e sulle tastiere di erogazione dei depuratori contaminati.
Nella seconda immagine, ecco lo
stesso punto dopo l’intervento
automatico di TYFON: nessuna
colonia visibile, nessuna proliferazione.
Solo un campo sterile e sicuro. Nessun altro sistema UV in uscita o ozono standard riesce a ottenere una neutralizzazione così visibile e
completa.
PRIMA vs. DOPO
E non finisce qui. Guarda gli
effetti su Pseudomonas
aeruginosa e Saccharomyces cerevisiae, batteri invisibili ma pericolosi per la salute dei tuoi clienti e la reputazione del tuo marchio.
Con TYFON, questi disgustosi agenti contaminanti vengono completamente abbattuti direttamente dall’ugello, senza rumori, senza odori, e senza nemmeno accorgersene.
PRIMA vs. DOPO
Nella foto a sinistra, il devastante attacco del Pseudomonas aeruginosai: un’esplosione batterica totale che ricopre ogni millimetro della piastra.
Sembra un campo di battaglia contaminato – ed è ciò che potrebbe accadere ogni volta che il tuo cliente beve da un erogatore non protetto.
A destra, dopo l’effetto Tyfon: la piastra è limpida, sterile, pura. Nessuna crescita. Nessuna
contaminazione. Nessuna minaccia.
Risultato clinico certificato dal Dipartimento di Medicina e Chirurgia dell’Università di
Milano-Bicocca.
E ora chiediti: cosa stai facendo bere davvero ai tuoi clienti?

PRIMA vs. DOPO
Guarda l’immagine di sinistra: il colore verde rappresenta la proliferazione incontrollata dello
Staphylococcus aureus.
Una vera e propria epidemia in miniatura, cresciuta in appena due ore.
Adesso guarda a destra.
Con Tyfon, non esiste. Lo stesso test. Lo stesso batterio. Ma con Tyfon attivo… la superficie
è vuota. È disarmante. È scioccante.
La differenza tra le due piastre è
la stessa differenza tra una
recensione 5 stelle e una chiamata legale.
E quando il tuo cliente scopre cos’ha bevuto… non sarà più un cliente.
TYFON® è il primo sistema d’igiene certificato medicalmente che dimostra nero su bianco cosa vuol dire protezione reale: basta guardare le immagini sopra. . .
Laddove gli altri sistemi lasciano proliferare batteri pericolosi, TYFON li neutralizza senza pietà
Il risultato? Clienti finali più felici, nessun rischio per la tua reputazione, margini di guadagno più alti per te e un vantaggio competitivo che nessun tuo concorrente può replicare.
Il Genio Nascosto Dietro Le Più Grandi Innovazioni Sugli Erogatori D’acqua
Ora Ti Mette In Mano La Più Potente;

TYFON
Chi c’è dietro Tyfon®? Solo uno dei più grandi innovatori che il settore abbia mai conosciuto.
Paolo Tesi non è semplicemente “uno” del settore.
È “il” settore.
Dal 1995, questo pioniere dell’innovazione ha rivoluzionato l’intero mercato dei frigo-gasatori e degli erogatori d’acqua con tecnologie che hanno generato milioni di euro per imprenditori come te – professionisti che ogni giorno noleggiano erogatori ai clienti finali.
È stato il primo al mondo a introdurre la sanificazione all’ozono negli impianti.
È l’inventore del sistema a chip card per la gestione intelligente degli erogatori.
È stato il primo a portare il touch screen nel mondo del trattamento acqua.
Ha costruito macchine che ancora oggi, dopo più di 15 anni, funzionano senza cedimenti, diventando veri monumenti di affidabilità.
Le sue creazioni tecnologiche sono così avanzate che oggi vengono utilizzate come modello dai colossi internazionali e compaiono nei cataloghi delle multinazionali più importanti del settore.
Tre aziende fondate da zero, portate al successo e vendute a gruppi industriali.
E oggi Paolo Tesi è alla guida della sua quarta creatura: Onnwater®.
Un’impresa familiare, costruita con suo figlio e sua moglie, dove ha riversato tutta la sua esperienza, visione e know-how tecnico accumulato in oltre 30 anni di innovazione.
E non ti sto raccontando tutto questo per glorificare Paolo
Ma per farti capire una verità essenziale: nessun altro, oggi, ha l’esperienza tecnica, la credibilità e la capacità visionaria per creare un sistema rivoluzionario come Tyfon®.
E considerando che dal 1995 le sue invenzioni hanno trasformato centinaia di attività nel tuo stesso settore in aziende milionarie, capaci di imporsi sul mercato, fare margini stellari e distruggere ogni forma di concorrenza…
…se io fossi in te, ovvero una persona che guarda lontano, mi sentirei incredibilmente al sicuro nel mettere Tyfon® a catalogo.
Perché quando scegli Tyfon®, non stai acquistando semplicemente un prodotto.
Stai scegliendo di metterti nelle mani dell’unico innovatore del settore che ha già fatto vincere centinaia di imprenditori come te.
Per Quanto Resterà Pulita la Tua Reputazione?
Ignorare la Retro-Contaminazione Può Essere l’Errore Che Distrugge il Tuo Business Di Erogatori D’acqua
Quando Meno Te lo Aspetti…






Se noleggi erogatori d’acqua ai clienti finali, allora devi sapere una cosa.
Non è una questione di se succederà.
È solo questione di quando…
La retro-contaminazione batterica non è una minaccia futura.
È un pericolo presente. Silenzioso.
Già in agguato.
Sta succedendo. Anche adesso. Anche dove meno te lo aspetti...
E quando colpisce…
non dà preavviso.
Ma la tua reputazione sarà già infettata.
Come una macchia tossica impossibile da rimuovere.
Può cancellare in un istante la fiducia costruita in anni.
Farti perdere clienti strategici.
Tagliarti fuori da gare pubbliche, appalti, contratti ricorrenti.
E tutto questo…
per colpa di un errore invisibile.
Tutto parte da punti che nessuno sospetta:
tastiere e pulsanti degli erogatori d’acqua, vaschette di raccolta e punti di uscita dell’acqua (ugelli di erogazione)
Zone umide. Esposte.
Toccate da mani sporche. Da borracce contaminate.
Perfette per ospitare colonie di batteri.
Batteri che portano nomi da incubo:
Staphylococcus aureus. Pseudomonas aeruginosa. Saccharomyces cerevisiae.
Questi microrganismi formano il biofilm:
una pellicola viscida che li nutre, li protegge…
e li rende praticamente invincibili.
Poi iniziano a risalire.
Dal punto di erogazione — dove l’acqua è appena stata filtrata —
penetrano nel sistema…
e lo contaminano dall’interno. Dopo che l’acqua è stata filtrata
Significa che i filtri dell’erogatore non hanno il potere di impedire la retro contaminazione perché essa avviene dopo il processo di filtrazione
Quindi l’acqua sembra pura.
Il cliente si fida.
La beve.
E tu?
Hai appena servito un bicchiere contaminato.
Senza saperlo.
Hai appena messo in pericolo la sua salute.
Hai compromesso il tuo lavoro, la tua reputazione, la tua azienda.
Ma ascoltami bene: non è colpa tua.
Il problema è che l’intero settore che produce erogatori d’acqua è tecnicamente arretrato.
Le soluzioni che stai usando non sono sbagliate.
Sono solo… insufficienti.
Nemmeno i grandi marchi sanno davvero come fermare la contaminazione batterica esterna.
Perché molti impianti sono progettati da ex ingegneri dell’automotive, del beverage, del freddo industriale…
Bravi, certo. Ma totalmente ignoranti sulle dinamiche batteriche specifiche dell’acqua potabile.
E quindi?
Cosa succede?
Succede che si copiano l’un l’altro.
Riciclano schemi vecchi.
Nascosti sotto etichette moderne.
Soluzioni inefficaci, che sembrano nuove. Ma non lo sono.
E intanto…
tu continui a installare impianti identici a quelli dei tuoi concorrenti.
Impianti a grave rischio di retro-contaminazione batterica
Impianti che non ti distinguono.
Impianti che ti costringono a giustificare un prezzo più alto —
senza avere nulla in più da offrire.
E così…
Ti ritrovi davanti clienti diffidenti.
Che ti mettono in discussione.
Che paragonano i tuoi erogatori ad altri simili — ma più economici.
E tu perdi.
Margini.
Fatturato.
Tempo.
Reputazione.
E tutto questo accade…
mentre vivi ogni installazione con l’ansia di una possibile retro-contaminazione.
Hai lavorato una vita per costruire un’azienda solida.
Hai fatto rinunce.
Hai sacrificato tempo prezioso con chi ami.
Hai investito tutto in un business che credevi sicuro.
E adesso?
Adesso sei lì.
Appeso a un filo.
Vulnerabile.
Non per un errore tuo.
Ma per un errore di chi ha progettato un intero settore su fondamenta sbagliate.
Lo so.
Non è giusto.
Ma è la realtà.
Ed è una realtà che non aspetta.
Perché il giorno in cui questa realtà ti travolgerà…
potrebbe arrivare molto prima di quanto pensi.
Le 2 Tecnologie Più Superate
Contro La Retro-Contaminazione:
Le Stai Ancora Usando?
Aspetta un attimo prima di pensare che le tecnologie che stai usando oggi siano davvero efficaci contro la retro-contaminazione...
Perché tra poco ti mostrerò cosa sta già minando i tuoi erogatori d’acqua dall'interno… e come Tyfon® ha risolto una volta per tutte ciò che altri produttori ancora ignorano.
Per anni ci hanno detto che le lampade UV in uscita erano “la” soluzione contro la retro-contaminazione batterica.
Ma ora sappiamo una verità scomoda che in pochi hanno il coraggio di ammettere:
Non solo le lampade UV in uscita sono superate…
…ma possono diventare una trappola micidiale per chi ancora ci crede.
E il prezzo da pagare non è solo tecnico. È economico, commerciale, reputazionale.
Primo punto critico: consumano energia continuamente.
Devono restare sempre accese per garantire la loro efficacia, un’assurdità in un mondo dove ogni watt conta.
Secondo: la manutenzione è un incubo.
Vanno cambiate ogni anno. Ma non lo può fare chiunque.
Serve esperienza. Serve tempo. Serve il tecnico giusto.
E quando qualcosa va storto – magari davanti al cliente – perdi la faccia prima ancora del contratto.
❝Perché devo cambiare una lampada che nemmeno sapevo ci fosse?❞
Una domanda semplice… ma devastante per la fiducia che il cliente ha in te.
Il problema peggiore? L’efficacia.
Funzionano solo dove arriva la luce. E la luce non arriva ovunque.
Angoli bui, superfici irregolari, micro-spazi invisibili… sono rifugi perfetti per i batteri.
E lì dentro, l’infezione continua a crescere, indisturbata.
Una sola zona non trattata… basta a contaminare tutto il resto.
E se pensi che i generatori d’ozono siano la soluzione… Attenzione.
Per essere veramente efficaci, dovrebbero emettere ozono oltre i limiti legali.
Ma a quel punto diventano illegali. E pericolosi.
Lo sapevi? In alcuni Paesi persino le stampanti laser devono essere isolate…
…perché emettono micro-dosi di ozono.
E tu installeresti un generatore d’ozono in uscita… accanto all’acqua che il tuo cliente beve?
In più, i generatori lavorano a 220 volt. A diretto contatto con l’acqua.
basta che la valvola di non ritorno perda tenuta
e l’acqua risale nel dispositivo, guastandolo irrimediabilmente
e rischiando Un corto circuito.
Un guasto banale come questo… e sei in prima pagina sui giornali.
Tutto questo è la cruda verità su tecnologie che sembrano sicure.
Ma non lo sono.
E ora che lo sai…
Capirai perché Tyfon® è nato per fare piazza pulita di tutto questo.
E tra pochi secondi ti spiegherò esattamente cosa rende Tyfon®
l’unico sistema igienico certificato al mondo che funziona davvero.
Vai avanti a leggere. . .
La Cosa Davvero Straordinaria?
È Che TYFON® Stermina i Batteri in Pochi Secondi… Senza Fare
Rumore, Senza Odore, E Senza Manutenzione Da Parte Tua
E adesso immagina questo. . .
Un sistema invisibile. Automatico. Infallibile.
Che non devi configurare. Non devi controllare. Non devi nemmeno ricordare che esiste.
Eppure, c’è.
Sempre lì.
Sempre attivo.
Sempre al tuo fianco.
Ogni volta che l’acqua esce dal punto di erogazione…
TYFON® si attiva.
Disinfetta. Protegge. Difende.
Ma lascia che sia chiaro fin da subito:
Non stiamo parlando di un accessorio.
Non è un “optional”. Non è un “plus”.
È un sistema di difesa invisibile che entra in azione prima ancora che il pericolo si manifesti.
E colpisce esattamente dove i batteri si annidano:
• Ugello di erogazione (il punto da cui esce l’acqua)
• Vaschetta di raccolta gocce
• Pulsanti
Tre punti deboli.
Tre aree dimenticate.
Tre rischi che oggi stanno esponendo la tua reputazione senza che tu lo sappia.
Ma con TYFON®…
Questa minaccia viene neutralizzata all’origine.
Prima che possa salire.
Prima che infetti.
Prima che rovini tutto ciò che hai costruito.
Zero rumore.
Zero manutenzione.
Zero alterazioni del gusto.
Zero segni della sua presenza.
Ma un’efficacia che lavora in silenzio.
Anche quando tu te ne sei dimenticato.
Lo fa con tre armi letali per i germi:
• Ozono (in micro-dosi legali in tutto il mondo)
• Radicali OH
• Ioni attivi
Tre elementi che in pochi secondi distruggono i batteri, proteggono il tuo impianto, e alzano lo scudo sulla tua
reputazione.
Letali per i germi.
Innocui per l’uomo.
Straordinari per il tuo business.
Questo è TYFON®.
Una barriera automatica.
E’ la differenza silenziosa tra chi spera che tutto vada bene…
…e chi si assicura che lo sia.
Il Segreto Scientifico
Di Come TYFON Protegge
Ogni Erogatore d’Acqua
E Ti Libera Per Sempre Dall’ansia
Della Retro-Contaminazione


Come Funziona TYFON?
Te lo spiego tra un attimo…
Ma prima lascia che ti dica cosa NON è
Perché è proprio qui che iniziano le sorprese
TYFON non è un generatore di ozono tradizionale:
non ci sono cavi, ingombri o complicazioni tecniche
Non devi montare nulla fuori. Non devi collegare nulla a parte
Non è nemmeno una lampada UV in uscita:
non va sostituita, non ha bisogno di manutenzioni continue
E non è il solito sistema invadente, difficile da spiegare al cliente finale
TYFON non altera il gusto dell’acqua
Non produce fumo. Non emette odori
E non genera residui tossici
Non è qualcosa che devi “aggiungere” al tuo impianto
È il contrario
È parte integrante dell’erogatore
Invisibile. Intelligente. Autonomo
E ora… ecco cosa fa
Basta una singola, minuscola goccia d’acqua
Quella che resta, invisibile, sull’ugello dopo ogni erogazione
Da lì, TYFON prende vita
Attraverso un processo brevettato e completamente automatico, quel micro-residuo si trasforma in tre potenti
elementi disinfettanti:
ozono, radicali OH, ioni
Tre agenti attivi
Tre guardiani invisibili
Tre nemici giurati della contaminazione
Non devi accenderlo
Non devi controllarlo
Non devi nemmeno ricordarti che esiste
Dopo ogni erogazione, appena l’acqua smette di scorrere…
TYFON si attiva
In silenzio
Senza odori
Senza rumori
E inizia il suo lavoro
Protegge ciò che nessun altro sistema considera:
• Il punto di uscita dell’acqua
• La vaschetta di raccolta gocce
• La tastiera e i pulsanti
Tre aree sempre umide, sempre esposte, sempre dimenticate
Tre varchi da cui i batteri tentano di rientrare
E da cui, troppo spesso, ce la fanno
Ma con TYFON, ogni tentativo viene bloccato all’origine
Subito. Immediatamente
I tre agenti formano uno scudo invisibile che neutralizza anche i batteri più resistenti:
Staphylococcus aureus, Pseudomonas aeruginosa, Saccharomyces cerevisiae
Se Puoi Contare Fino a 5
Puoi Installare TYFON. . .
Nessun Attrezzo, Nessun Tecnico
Nessuna Complicazione
Fisicamente TYFON è un micro-ago invisibile all’interno dell’ugello
Gestito da una scheda elettronica intelligente all’interno dell’erogatore, che regola tutto automaticamente
Non richiede manutenzione continua
Non ci sono pezzi da sostituire ogni anno
al massimo pulisci l’ugello una volta all’anno. Bastano 5 minuti. Nessun attrezzo
Ogni ugello ha il suo TYFON
Quindi se hai un impianto a doppia erogazione, avrai doppio TYFON e doppia protezione
Ma Se L’acqua In Entrata
Fosse Gia’ Contaminata?
Abbiamo pensato anche a quello.
TYFON lavora insieme a una lampada UV da 7 litri al minuto in linea e in entrata all’erogatore
installata proprio nel punto in cui entra l’acqua
Quella lampada sterilizza l’acqua in entrata. TYFON protegge quella in uscita
Anche l’acqua più filtrata può essere contaminata quando entra nell’erogatore
ecco perché la lampada UV in entrata è fondamentale per creare una sinergia
e una doppia protezione assieme a TYFON
Ma Perché TYFON Merita Davvero La Tua Attenzione?
Per Prima Cosa Grazie Alla Sua
CREDIBILITÀ ASSOLUTA.
Nessun Altro Sistema Contro
La Retro-Contaminazione Batterica
Al Mondo
È Mai Stato Certificato Da Enti Medici E Chirurgici.

È Solo Marketing? No. È Scienza. Ed È Inconfutabile.
La protezione automatica.
La tripla barriera contro i germi.
La sicurezza al 99.99999%
Non sono solo belle parole.
Sono prove. Fatti. Verifiche cliniche.
Perché TYFON® non è una promessa pubblicitaria.
È una tecnologia che ha superato ogni test.
E tra poco scoprirai un “prima e dopo” che ti farà riconsiderare ogni altra soluzione che hai proposto finora…
TYFON è Il primo — e unico — sistema per erogatori d’acqua con certificazione clinica universitaria.
Il Dipartimento di Medicina e Chirurgia dell’Università degli Studi di Milano-Bicocca — uno dei centri scientifici più
autorevoli in Europa — ha sottoposto TYFON® a una serie di test indipendenti, durissimi, in condizioni operative reali.
Cosa è successo?
Sono stati messi alla prova i tre ceppi batterici più pericolosi:
Staphylococcus aureus – si trasmette con uno starnuto. E resiste ovunque.
Pseudomonas aeruginosa – vive nei ristagni umidi. Crea biofilm invincibili.
Saccharomyces cerevisiae – fungo resistente, simbolo delle contaminazioni alimentari.
Il risultato? Eliminazione al 99.9999%
TYFON® ha annientato tutti i batteri. Anche a potenza intermedia.
Senza rumore.
Senza odori.
Senza superare i limiti di legge per l’ozono (<2,5 mg).
Tutti i test sono stati documentati su piastre di agar, fotografati, analizzati, verificati sotto microscopio.
Guarda tu stesso le foto del prima e dopo dell’effetto mortale che TYFON ha sui batteri responsabili della
retro-contaminazione

PRIMA vs. DOPO

PRIMA vs. DOPO
Le foto schiacciano ogni dubbio. Prima i batteri si vedevano. Dopo TYFON, non più.
Le lampade UV in uscita? Avrebbero lasciato zone d’ombra.
I generatori d’ozono classici? Avrebbero fallito per limiti tecnici e di legge.
Solo TYFON® ha protetto l’erogatore in ogni millimetro critico.
E lo ha fatto… in automatico.
E quando lo mostri al cliente? Il gioco cambia.
Con TYFON® hai in mano:
Un certificato medico firmato.
Un test universitario ufficiale.
Una prova visiva che zittisce ogni obiezione.
Non sei più uno qualunque.
Diventi “quello con la tecnologia clinicamente provata”.
Il professionista che sa proteggere, differenziare e vendere.
E così:
Giustifichi un prezzo più alto, senza dover abbassare la testa.
Vinci trattative dove i concorrenti mendicano attenzione.
Conquisti clienti che vogliono il meglio. Non il meno caro.
Con TYFON® non stai solo installando un impianto.
Stai blindando il tuo futuro.
Stai difendendo il tuo nome sul mercato.
Stai costruendo un’azienda che nessuna retro-contaminazione potrà mai mettere in crisi.
15 Ragioni Per Cui Dovresti Strisciare Sui Vetri Rotti Pur
Di Introdurre Tyfon Sui Tuoi Erogatori D’acqua.
Ecco Solo Alcuni Dei Benefici E Vantaggi Più Importanti
Che Puoi Ottenere Inserendo Tyfon® Nei Tuoi Impianti.
Ti Consiglio Di Spuntare Quelli Che Per Te Sono Più
Urgenti O Desiderabili:
15 Ragioni Per Cui Dovresti Strisciare Sui Vetri Rotti Pur Di Introdurre Tyfon Sui Tuoi Erogatori D’acqua.
Ecco Solo Alcuni Dei Benefici E Vantaggi Più Importanti
Che Puoi Ottenere Inserendo Tyfon® Nei Tuoi Impianti.
Ti Consiglio Di Spuntare Quelli Che Per Te Sono Più Urgenti O Desiderabili:
Tyfon® ti consente di chiudere più contratti, perché nessun concorrente può offrire una tecnologia così unica e certificata.
Tyfon® ti consente di alzare i tuoi margini, proponendolo come optional premium anche a 4 volte il prezzo d’acquisto.
Tyfon® ti consente di entrare negli ambienti più delicati – scuole, cliniche, RSA, ospedali – con una garanzia igienica
medicale senza pari.
Tyfon® ti consente di eliminare l’ansia delle analisi a sorpresa, perché protegge l’acqua anche dopo la filtrazione.
Tyfon® ti consente di salvare la tua reputazione da brutte sorprese, lamentele e contestazioni da parte di clienti
finali.
Tyfon® ti consente di presentarti con prove scientifiche vere, grazie a un report firmato da un’università.
Tyfon® ti consente di dare ai tuoi commerciali una leva potente, facile da spiegare, memorabile, vincente.
Tyfon® ti consente di vincere più gare d’appalto, soprattutto nei bandi in cui l’igiene fa la differenza.
Tyfon® ti consente di ridurre le manutenzioni, evitando ricambi continui, smontaggi e perdite di tempo.
Tyfon® ti consente di evitare figuracce davanti al cliente, dove ogni intervento tecnico trasmette incertezza.
Tyfon® ti consente di uscire dalla guerra del prezzo, distinguendoti nettamente da chi propone solo lampade UV.
Tyfon® ti consente di diventare il partner ideale per aziende che cercano sicurezza, innovazione e affidabilità.
Tyfon® ti consente di costruire un brand rispettato, ricordato e preferito anche con 3 preventivi più economici davanti.
Tyfon® ti consente di prevenire danni enormi, partendo da una sola goccia umida lasciata nella vaschetta.
Tyfon® ti consente di portare stabilità economica alla tua azienda, serenità al tuo team e prosperità alla tua famiglia.

Ma Andiamo Nello Specifico
Di Cosa Può Fare Tyfon®
Per Te
Nelle Situazioni Reali In Cui Ti Giochi Fatturato,
Reputazione E Credibilità
Ma Andiamo Nello Specifico
Di Cosa Può Fare Tyfon® Per Te
Nelle Situazioni Reali In Cui Ti Giochi Fatturato,
Reputazione E Credibilità

Ecco Alcune Situazioni Concrete In
Cui Tyfon® Può Diventare
La Tua Arma Segreta, Quella Che Fa Davvero La Differenza
Tra Restare “Uno Dei Tanti”…Oppure Posizionarti Come Leader
Nel Mercato Del Trattamento Acqua.
SITUAZIONE #1: QUANDO DEVI VENDERE IN UN MERCATO SATURO E COMPETITIVO
Cosa vuoi?
Vuoi differenziarti dalla concorrenza che propone sempre le stesse soluzioni (lampade UV e ozono), vendute al ribasso.
Vuoi avere un motivo concreto per non dover più combattere sul prezzo e portare a casa contratti a margine pieno.
Vuoi che il cliente ti scelga anche se ha in mano 3 preventivi più bassi del tuo.
Tyfon® è il tuo elemento differenziante certificato, un monumento tecnologico che nessun concorrente può replicare.
SITUAZIONE #2: QUANDO HAI PAURA DI METTERE A RISCHIO LA TUA REPUTAZIONE
Hai mai installato un impianto e temuto che qualcosa potesse andare storto?
Un cliente che fa un’analisi? Un piccolo batterio che rovina tutto?
Tyfon® ti consente di azzerare il rischio retro-contaminazione e dormire sonni tranquilli, perché ogni erogazione è protetta da un sistema invisibile, ma attivo H24.
Reputazione salva. Clienti sereni. Tecnici sicuri.
SITUAZIONE #3: QUANDO VUOI ENTRARE IN SCUOLE, OSPEDALI, CLINICHE
In questi ambienti non basta una bella brochure.
Servono certificazioni vere, prove al microscopio, tecnologie che rispettano i protocolli medici.
Tyfon® è l’unico sistema per retro-contaminazione certificato a livello medicale da un’università.
Significa che puoi vincere più gare, entrare nei bandi più selettivi, e posizionarti come fornitore ufficiale in contesti ad alto valore.
SITUAZIONE #4: QUANDO DEVI DIFENDERTI DALLO STRESS E DAI MARGINI DI GUADAGNO CHE CROLLANO
Ogni chiamata in assistenza è stress.
Ogni componente da sostituire è un costo.
Ogni cliente insoddisfatto è una mina alla tua stabilità aziendale.
Tyfon® funziona senza manutenzione, senza sostituzioni annuali, senza odori né rumori, e non altera il gusto dell’acqua.
È un sistema automatico, che ti toglie lavoro e ti aggiunge valore.
SITUAZIONE #5: QUANDO VUOI DAVVERO CRESCERE NEL TUO MERCATO E OLTRE, SENZA ACCONTENTARTI
Vuoi più clienti, più contratti, più guadagni.
Ma ogni volta che devi giustificare il prezzo, O competere sullo stesso terreno degli altri… perdi slancio.
Tyfon® ti permette di proporre una tecnologia premium, vendibile anche al 400% del costo, che giustifica il prezzo, aumenta il valore percepito e aumenta i tuoi margini senza aggiungere sforzi. È un moltiplicatore di fatturato che lavora per te.
Ma Quanto Costa TYFON?
Il Sistema Di Sanificazione Più Costoso Al Mondo. . .
Eppure Sempre Più Installatori
Lo Scelgono Ogni Settimana.
Perché?
Il Sistema Di Sanificazione Più Costoso Al Mondo. . .
Eppure Sempre Più Installatori Lo Scelgono Ogni Settimana.
Perché?
La vera domanda NON è “quanto costa Tyfon®?”
La vera domanda è:
Quanto vale, oggi, la tua tranquillità?
E la tua reputazione nel mercato?
Quanto vale sapere (NON SPERARE)
che ogni erogatore che stai installando è blindato contro i batteri?
Che nessun cliente potrà accusarti.
Che nessuna analisi potrà rovinarti l’immagine.
Che nessun appalto o contratto potrà più sfumare per colpa di un’incertezza tecnica.
Che non verrai mai più escluso da ospedali, scuole o cliniche...
solo perché non hai potuto dimostrare di avere una protezione reale contro la retro-contaminazione
Ecco il punto.
Quanto vale avere in mano l’unico sistema al mondo...
...certificato da un dipartimento medico-chirurgico universitario.
...progettato per renderti inattaccabile.
...capace di difendere la tua immagine professionale e farti chiudere più contratti
Se guardi le cose da questo punto di vista...
Tyfon® non è un costo.
È una polizza sulla tua carriera.
È una leva commerciale.
È uno scudo strategico.
E chi lo conosce davvero... lo paga.
550€, senza battere ciglio.
Si, 550€ È il prezzo che pagano ogni giorno i distributori ufficiali Onnwater.
Quelli che NON stanno vedendo questa pagina.
Quelli che acquistano regolarmente a queste condizioni.
Perché conoscono il suo valore unico.
Ma tu oggi hai un’opportunità diversa.
Solo su questa pagina.
Solo in fase di lancio.
Solo per chi agisce adesso.
Fermati un secondo.
Respira.
E rifletti con lucidità.
249€... è meno di quanto ti costerebbe un solo intervento tecnico per sostituire una lampada UV.
È meno del costo di un reclamo di un cliente che trova batteri nell’acqua.
È meno di quanto perderesti non vincendo una gara pubblica per mancanza di certificazioni.
Ma soprattutto...
249€ è un investimento che puoi trasformare in 500€ di ricavo netto a ogni installazione.
Hai letto bene. 500€ è il prezzo al quale puoi proporlo ai tuoi clienti
Con lampade UV in uscita o generatori di ozono...
non potresti nemmeno sognare questi margini.
Pensa solo a questo:
quante lampade dovresti vendere per ottenere lo stesso utile?
Quanti ozonizzatori dovresti installare, per arrivare alla stessa cifra?
Non c’è dubbio che TYFON Ti fa guadagnare di più.
Ti fa chiudere più contratti.
Ti fa dormire meglio.
Non esiste nulla di simile al mondo.
Nessun sistema di igiene per erogatori d’acqua fa tutto questo.
E certamente... non a soli 249€
E adesso?
la domanda finale è una sola:
puoi davvero permetterti di NON avere TYFON nel tuo catalogo?
Ecco I Bonus GRATIS Che Trasformano TYFON®
Nel Tuo Passaporto Verso Margini Più Alti,
Reputazione D’Elite E Vendite Senza Concorrenti
Diventare Tyfon Partner non è solo una decisione tecnica.
È un passo audace verso un nuovo posizionamento, un nuovo margine, una nuova reputazione.
E per premiare chi fa questa scelta con coraggio – adesso, su questa pagina –
ho deciso di regalarti dei BONUS esclusivi che valgono molto più del prezzo stesso di Tyfon.
BONUS mai venduti separatamente, e progettati per farti guadagnare già da domani grazie a Tyfon.
Non si tratta di un semplice “materiale di supporto”.
Si tratta di un sistema di vendita, installazione e presentazione già pronto all’uso.
Creato per farti fare soldi extra sin dalla prima installazione.
E renderti inarrestabile di fronte a qualsiasi concorrente.
Ecco I BONUS Che Ricevi IN REGALO Solo Se Richiedi Tyfon Adesso
E Prima Che Si Esauriscano I 100 Posti Partner Nel Mondo:


Che normalmente è venduta a 160€
Anche l’acqua filtrata in entrata può nascondere minacce invisibili.
Per questo, per ogni erogatore che ordini con il Tyfon, ricevi GRATIS una lampada UV integrata nell’erogatore che sterilizza l’acqua in ingresso. Una doppia protezione - ingresso e uscita - che garantisce sicurezza totale e differenziazione dalla concorrenza.


Che normalmente è venduta a 1.500€
Scopri come presentare Tyfon come la scelta preferita dei tuoi clienti, anche per i clienti più scettici.
Questo video corso che RICEVI GRATIS creato da Fabio Tesi ti fornisce tecniche di vendita, testi pronti all’uso e strategie per giustificare il prezzo
premium di Tyfon senza esitazioni.


Che normalmente è venduta a 299€
RICEVI GRATIS Una certificazione medica, spiegata in termini semplici, impaginata con il tuo brand e pronta da consegnare e mostrare ai tuoi clienti finali.
Aumenta l’autorevolezza e giustifica un prezzo più alto senza sforzo. . .perchè con il dipartimento
medico chirurgico dell’università di Milano non si discute.


Che normalmente è venduta a 99€
Sostituire Tyfon è più semplice che cambiare un filtro.
Con questo video tutorial che RICEVI GRATIS, anche il tecnico meno esperto può farlo in meno di 5 minuti, eliminando rischi e necessità di assistenza complicata.


Che normalmente è venduta a 100€
Ricevi GRATIS una brochure professionale, graficamente curata, con i tuoi dati aziendali e tutte le informazioni su Tyfon.
Pronta da inviare, stampare e mostrare ai tuoi clienti.


Che normalmente è venduta a 1.500€
Ricevi GRATIS un breve video emozionale e autorevole che puoi inviare via WhatsApp, email o mostrare durante la trattativa.
Tyfon si presenta da solo, meglio di qualsiasi venditore.


Che normalmente è venduta a 300€
Ricevi GRATIS un pacchetto di immagini pronte, con il tuo logo, per comunicare Tyfon sui social o nelle presentazioni.
Usale dove vuoi, quando vuoi.


Che normalmente è venduta a 99€
Ricevi GRATIS una tabella visiva pronta da mostrare al cliente finale, per far capire al volo perché Tyfon è superiore a qualsiasi lampada UV in uscita o generatore di ozono.


Valore INESTIMABILE
Ricevi GRATIS un adesivo professionale, numerato e unico al mondo, da applicare su ogni impianto. Segnala al cliente finale che sta bevendo da un impianto esclusivo, protetto da Tyfon, installato da uno dei soli 100 partner al mondo autorizzati.
(normalmente venduto a…………..)
Ma ora preparati perché è richiesta la tua velocità, infatti esiste un


Che normalmente è venduta a 400€
Solo i primi 20 che richiedono Tyfon oggi tramite questa pagina ricevono GRATIS la versione cartacea e rilegata del corso di vendita che ti mostra le tecniche per proporre al meglio TYFON
e ottenere il massimo profitto, è una guida pronta da consultare, sottolineare, portare in trattativa. Solo 20 copie.
Non verranno mai ristampate.
Chi prima agisce… vince.
Questi bonus da soli valgono 4.457€…
…e sono tuoi gratuitamente, solo diventando Tyfon Partner tramite questa pagina.
Se far crescere il tuo business degli erogatori d’acqua è una tua priorità – allora questi bonus, uniti al potere esclusivo di Tyfon e alla garanzia più forte del settore, rendono questa offerta un vero e proprio “no-brainer”.
Un pacchetto completo, pronto all’uso, pensato per farti chiudere più contratti, con margini più alti e senza più concorrenti a metterti in difficoltà.
Ma attenzione: questi bonus non sono acquistabili separatamente, e sono riservati solo ai pochi che entreranno ora nel gruppo selezionato dei 100 Tyfon Partner globali.
Se ne vuoi anche solo uno… devi agire ora.

ATTENZIONE:
Tyfon® NON Sarà Disponibile Per Sempre
Se stai anche solo considerando l’idea di rimandare questa decisione… fermati adesso.
Perché questa non è una classica promo a tempo.
Non stiamo parlando di uno sconto che finirà tra una settimana.
Tyfon® è un sistema esclusivo. Ma esclusivo davvero
Onnwater ha deciso di bloccare le vendite una volta raggiunti 100 partner ufficiali nel mondo.
Dopo quel punto, Tyfon® non sarà più vendibile. A nessuno. A nessun prezzo. A nessuna condizione.
Fine. Stop.
Porta chiusa per sempre.
Non ci sarà nessuna seconda possibilità.
E per rendere questa scelta visibile e ufficiale, ad ogni erogatore d’acqua dotato di Tyfon® verrà fornito di un adesivo certificato con la numerazione esclusiva:
“Tyfon® Partner 1 di 100”. . . “Tyfon® Partner 2 di 100”. . . . “Tyfon® Partner 3 di 100”. . . e così via fino ad un massimo di 100 partner
Un simbolo concreto da applicare sull’erogatore.
Una prova tangibile da mostrare ai tuoi clienti.
Un sigillo di prestigio, che nessuno dei tuoi concorrenti potrà mai imitare.
Ma ora viene il punto critico...
Ti sembrano tanti, 100 partner?
Allora considera questo:
Onnwater ha già 387 distributori ufficiali nel mondo.
Molti di loro hanno già avviato l’inserimento di Tyfon® a catalogo.
I posti reali disponibili sono pochissimi.
Ogni ora che passa, uno di quei 100 slot viene bruciato da chi si muove più veloce di te.
E mentre tu stai ancora leggendo, qualcuno ha già preso una decisione.
Se aspetti, Tyfon® finirà.
Se perdi l’occasione, perderai l’accesso a uno dei pochi strumenti veramente esclusivi e certificati nel mondo della retro-contaminazione batterica.
E perderai l’opportunità di differenziarti per sempre, chiudere più contratti, vincere più gare d’appalto, alzare i margini e blindare la tua reputazione con una leva commerciale che solo 100 partner al mondo potranno usare.
Ogni minuto che lasci passare è un minuto in cui qualcun altro prende la tua posizione tra i 100 partner esclusivi.
E quando il portone si chiuderà…
potrai solo guardare da fuori chi si prende i successi che spettavano anche a te e passerai il resto della tua carriera in questo settore a chiederti “perché non ho agito prima”…e convivere con la risposta e il rimorso straziante di non aver agito.
Anzi. . . la probabilità che tu già adesso sia fuori dai 100 partner esclusivi per tyfon è estremamente alta, quindi ti consiglio di metterti fretta e chiamare il numero qui sotto per non rimanere a guardare gli altri che si prendono il successo che spettava a te.
Perché Alcune Persone
Non Potranno Mai Avere Tyfon
Per diventare Tyfon Partner NON servono numeri minimi d’acquisto riguardo agli erogatori
Ma c’è una condizione non negoziabile.
Una condizione che — se non rispetti — ti esclude all’istante da questa opportunità.
Tyfon® deve essere incluso su ogni singolo erogatore sopra banco che ordini da Onnwater.
Tutti. Nessuno escluso.
Perché Tyfon® non è un optional.
Non è un’aggiunta. Non è un lusso.
È un’identità.
Se pensi che Tyfon® sia solo un “valore aggiunto”, da installare su richiesta o “quando capita”...
allora Tyfon® NON fa per te.
Perché chi vuole DAVVERO distinguersi sul mercato, non lo fa una volta sì e una no.
Lo fa sempre.
Lo fa con ogni cliente.
Lo fa con ogni erogatore.
Diventare un Tyfon Partner non significa aggiungere un prodotto a catalogo.
Significa fare una scelta di campo.
È dire al mercato:
“Io non sono come gli altri.
Io non lotto sul prezzo.
Io offro qualcosa che nessun altro può nemmeno toccare.”
E se questa non è la tua visione, va bene così.
Là fuori c’è spazio per chi si accontenta.
Per chi spera.
Per chi aspetta che vada tutto bene da solo.
Anzi, lascia che te lo dica chiaro:
Se vedi Tyfon come un optional, hai appena risparmiato 249€. Perché non dovrai mai acquistarlo
E vale anche per la tua tranquillità contro la retro-contaminazione batterica
Perché se vuoi proteggere la tua reputazione… se vuoi che i tuoi erogatori siano sicuri e non invasi dai batteri lo vuoi
SEMPRE.
Non oggi sì e domani no.
La salute dei tuoi clienti non è negoziabile.
La tua immagine professionale nemmeno.
Se pensi che siano “importanti ma non sempre”, allora Tyfon non è per te.
Ma se dentro di te senti quella fame che solo chi vuole dominare conosce…
Se vuoi diventare IL riferimento per igiene, sicurezza e tecnologia…
Se vuoi chiudere più contratti, con più margini e zero reclami…
Allora questa è la tua occasione.
Diventa uno dei soli 100 Tyfon Partner al mondo.
Trasforma ogni tuo erogatore in una leva commerciale che nessun concorrente può replicare.
Ma decidi ora.
Perché mentre leggi queste righe...
uno dei 100 posti potrebbe essere già svanito.
Ti Garantisco Che Se Installi Tyfon
E Le Analisi Dell’acqua Dei Tuoi Clienti Falliscono
Ti Mando Un Tecnico In Sede
Che Revisiona E Sostituisce Tutto Il Sistema GRATIS
Fino A Che Le Analisi Non Tornano Negative.


So perfettamente cosa potresti pensare.
“E se poi Tyfon non funziona davvero come promesso?”
È una domanda legittima. Anzi, è la domanda giusta.
Ma proprio per questo… non ti sto chiedendo di fare un salto nel vuoto.
Ti sto chiedendo di prendere una decisione solida.
Protetta. Difesa. Garantita.
E ora lascia che ti dica la verità — nuda e cruda:
Se installando un erogatore sopra banco Onnwater…
...seguendo le istruzioni indicate...
...con la lampada UV in entrata (che ricevi gratuitamente)…
...e con Tyfon montato e attivato…
E se, nonostante tutto questo, il tuo cliente finale fa delle analisi…
...e da quelle analisi emerge la presenza di batteri pericolosi come Pseudomonas aeruginosa, Staphylococcus aureus o Saccharomyces cerevisiae...
Ecco cosa succede, senza se e senza ma:
Mandiamo un tecnico Onnwater direttamente nella tua sede. (o quella del tuo cliente)
Il tecnico revisiona l’intero impianto da cima a fondo.
Sostituisce a nuovo tutto quello che c’è da sostituire.
E lo fa completamente GRATIS.
Fino a quando?
Fino a quando le analisi non saranno perfettamente negative.
Fino a quando il tuo cliente non potrà dirsi pienamente soddisfatto.
Fino a quando tu non potrai tornare a dormire sereno.
Senza moduli da compilare.
Senza procedure.
Senza lungaggini burocratiche.
O Tyfon funziona come ti abbiamo promesso…
...oppure ce ne occupiamo noi, finché funziona alla perfezione.
E tu non spendi un centesimo in più.
Questa non è solo una garanzia.
È una presa di responsabilità.
Ed è anche il motivo per cui Tyfon è oggi l’unico sistema antibatterico per erogatori certificato a livello medicale.
D’altronde… pensaci un attimo:
Se Tyfon non funzionasse davvero…
...credi che Onnwater sarebbe ancora qui?
...credi che potremmo permetterci una garanzia del genere?
...credi che potremmo sostituire impianti gratuitamente senza fallire?
No. Non potremmo. E non lo faremmo.
Ma lo facciamo perché sappiamo che Tyfon funziona. Sempre. Come promesso.
E molto presto, lo saprai anche tu.
Ecco Un Riassunto Di Tutto Quello Che Ottieni Oggi
Solo Se Richiedi Adesso Tyfon Tramite Questa Pagina:
Quindi, facciamo un riassunto di tutto quello che ottieni oggi solo se richiedi adesso Tyfon tramite questa pagina:
Il prezzo di Tyfon bloccato a vita:
A soli 249€ anziché 550€
In più. . .
Ricevi GRATIS tutti questi bonus:


BONUS GRATIS #1
Lampada UV In Linea Da 7 Litri Al Minuto Per Sterilizzare l’Acqua In Entrata
Valore: 160€

BONUS GRATIS #2
Video Corso “TYFON SELLING FORMULA” per vendere facilmente Tyfon
Valore: 1.500€

BONUS GRATIS #3
Certificazione Medica di TYFON personalizzata, semplice da presentare
Valore: 299€

BONUS GRATIS #4
Video tutorial installazione e sostituzione in meno di 5 minuti
Valore: 99€

BONUS GRATIS #5
Brochure Tyfon con il tuo logo, pronte all’uso
Valore: 100€

BONUS GRATIS #6
Video promozionale personalizzato con il tuo marchio
Valore: 1.500€

BONUS GRATIS #7
Immagini promozionali brandizzate
Valore: 300€

BONUS GRATIS #8
Tabella comparativa per distruggere i tuoi concorrenti
Valore: 99€

BONUS GRATIS #9
Il sigillo ufficiale numerato da partner Tyfon (solo 100 al mondo)
Valore Inestimabile

BONUS GRATIS #10
Il manuale cartaceo per vendere Tyfon con il massimo profitto
Valore: 400€ - solo per i primi 20
Tutto questo normalmente avrebbe un valore complessivo di 4.457€…
Ma se chiami adesso, e ripeto adesso, hai tutto a soli 249€, prezzo bloccato a vita.
E naturalmente, incluso anche il nostro sistema di garanzia totale:
Se Tyfon non funziona… siamo noi a intervenire, a spese nostre, fino a che le analisi non tornano perfette. Nessun modulo. Nessuna
scusa. Solo risultati.
Chiama ora. Blocca il tuo posto. E prendi ciò che ti meriti.

Ecco Precisamente Cosa Fare Ora:
Se sei arrivato fin qui, non è un caso.
Qualcosa dentro di te ti sta già dicendo che Tyfon® è ciò che stavi cercando per proteggere la tua reputazione, distinguerti sul mercato e blindare la tua azienda dai rischi della retro-contaminazione.
Bene.
Adesso è il momento di agire.
Chiama subito il tuo Advisor Onnwater al numero:
+39 388 897 6879
(o scrivi una mail a [email protected] con oggetto: “Richiesta Tyfon”)
Non aspettare. Non rimandare.
Ogni minuto che passa, una nuova azienda si sta candidando per diventare Tyfon Partner™.
E ricordalo: una volta raggiunti i 100, le porte si chiudono. Per sempre.
La giornata in cui Tyfon arriverà nelle tue mani sarà l’inizio di una nuova fase per il tuo business: più forte, più profittevole, più rispettato.
Perché mentre gli altri ancora parlano di igiene, tu potrai dimostrarla. Scientificamente.
Chiama subito il tuo Advisor Onnwater al numero:
+39 388 897 6879
(o scrivi una mail a [email protected] con oggetto: “Richiesta Tyfon”)

P.S.
TI riassumo i vantaggi che ottieni per TYFON solo se lo richiedi tramite questa pagina:
L’accesso a Tyfon®, l’unico sistema certificato a livello medicale contro la retro-contaminazione batterica.
Il prezzo lancio irripetibile di soli 249€, contro i 550€ pagati da tutti gli altri partner.
L’ingresso nel gruppo esclusivo dei 100 Tyfon Partner™, con adesivo numerato per mostrare ai clienti il tuo status di esclusività e diventare imparagonabile a chiunque 10 bonus GRATIS esclusivi, tra cui:
La lampada UV in entrata in regalo inclusa nel prezzo
Il video-corso per vendere Tyfon al doppio del prezzo senza resistenze
La brochure e il video promo personalizzati
Il certificato da dare al cliente finale
Il manuale fisico “TYFON Selling Formula™” (solo per i primi 20)
...e molto altro ancora.
Ma se non agisci ORA, e decidi di “pensarci su”…
Potresti perdere tutto.
Potresti essere tagliato fuori dai 100 partner selezionati.
Potresti continuare a installare impianti vulnerabili, con il rischio reale di analisi batteriologiche positive.
Potresti restare uno dei tanti, senza l’arma definitiva che dimostra – nero su bianco – la tua superiorità tecnica.
Potresti dover spiegare al tuo prossimo cliente perché lui ha trovato un concorrente che presenta un certificato medico universitario... e tu no.
E intanto, i tuoi competitor stanno leggendo questa stessa pagina.
Stanno chiamando.
Stanno prendendo i posti disponibili.
E potrebbero chiuderti la porta in faccia per sempre.
Vuoi davvero correre questo rischio per un prodotto che ti fa guadagnare di più, ti difende legalmente e ti distingue in modo inattaccabile?
Chiama ORA.
Diventa Tyfon Partner™.
Non lasciare che lo diventi il tuo concorrente.
Chiama subito il tuo Advisor Onnwater al numero:
+39 388 897 6879
(o scrivi una mail a [email protected] con oggetto: “Richiesta Tyfon”)
Privacy Policy | Cookies Policy | P.IVA/CF 01812830097
©2025 – Onnwater | Tutti i diritti sono riservati
Privacy Policy | Cookies Policy | P.IVA/CF 01812830097
©2025 – Onnwater | Tutti i diritti sono riservati